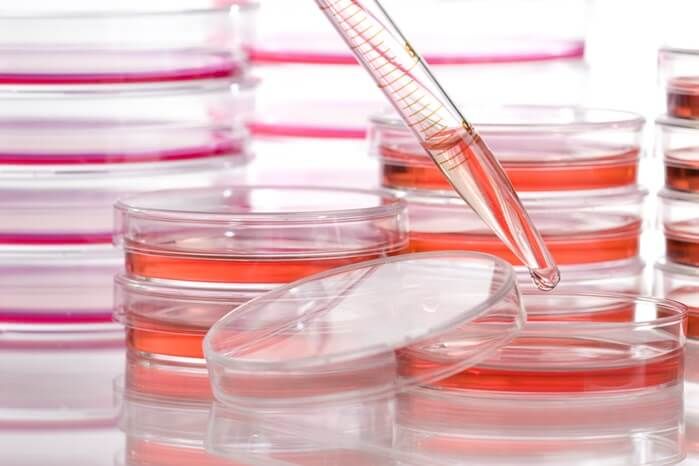

醫療器材 生物相容性試驗 (Biocompatibility)
生物相容性是指醫療材料、機器、設備等,在特定應用及執行中引起宿主反應的能力,也就是指材料在正使用下中與生物體接觸後,是否會使得宿主產生恰當的反應,當宿主反應輕微、可耐受或是無不良反應時,則此種材料為生物體惰性之材料。而生物相容性測試的目的就是要確保人體在接觸到材料後,材質不會釋放有毒物質,造成局部或全身性細胞毒性、致癌性及生殖毒性,人體在接觸到材料後不會引起發炎反應、免疫反應、毒性反應、血栓形成反應等危害。
食藥署 TFDA 參照廣為國際衛生主管機關、學界和業界所使用的 ISO 10993 系列為規範標準,而醫療器材管理辦法主要參考美國 FDA,將醫療器材依據風險程度,分成下列三種等級:
第一等級:低風險性
第二等級:中風險性
第三等級:高風險性
只有第三等級和部分的第二等級產品上市前需執行臨床試驗,而這類醫療器材在申請臨床試驗時,也需要提供相關資料暨文獻,例如由符合優良實驗室操作規範(GLP)的實驗室提供臨床前試驗結果報告及非臨床安全性評估(生物相容性)以證明產品之安全性及品質。
依據身體接觸部位之醫療器材分類
醫療器材因不同產品有不同特性、效能、接觸之部位,因此在 ISO 10993-1 規範中,以人體接觸部位及接觸時間為基礎,依此設計實驗內容,即可確保最終商品使用於人體時其相容性狀態,以下為依據身體接觸部位之醫療器材分類資訊。
接觸體表之器材:
皮膚:各種電極、體外義肢、固定用膠布、壓迫性繃帶及監視器、熱敷墊。
黏膜:隱形眼鏡、導尿管、腸內醫療器材、氣管支管、牙內填料、齒列矯正醫材。
受傷體表:用於潰瘍、燒傷及肉芽組織之敷料或癒合醫材及封閉性貼布。
體外連通之器材:
非直接之血液路徑:體液輸入套(裝置)、轉接套、延伸套及血液輸入套(裝置)。
組織 / 骨頭 / 牙質:腹腔鏡、關節鏡、引流系統、牙科用黏粉、皮膚用釘針及牙科填充物。
循環血液:血液內導管、充氧氣、透析器及其配建、血液吸附器、免疫吸附器、暫時性心律調整器。
植入器材:
骨頭 / 組織:骨釘、骨板、人工關節、心臟節律器、藥物供應器、乳房植入物、人工肌腱、結紮夾。
血液:心臟節律器的電極、心臟瓣膜、人工血管、體內藥物輸送導管、心室輔助器材、人工動靜脈廔管。

你必須登入才能發表留言。